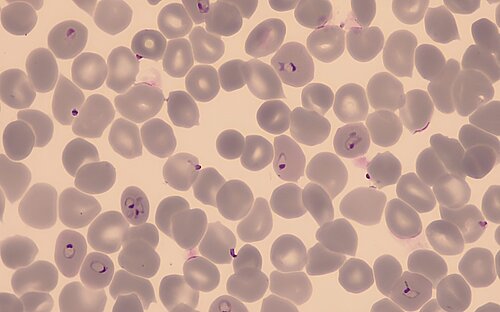

Malaria - kleiner Stich mit großer Wirkung

Malaria gehört gemeinsam mit Tuberkulose und AIDS zu den „großen Drei“, also den drei Infektionskrankheiten, die weltweit für die meisten Todesfälle verantwortlich sind. Die Weltgesundheitsorganisation schätzt, dass es im Jahr 2024 rund 282 Millionen Malariainfektionen und mehr als 600.000 Todesfälle gab. Mehr als 90 % der Infektionen und Todesfälle treten in Afrika auf. Vor allem Kinder sind gefährdet, da ihr Immunsystem die Krankheit noch nicht kennt.
Die Ansteckungsgefahr ist besonders in der Nacht erhöht: Dann stechen die Anophelesmücken und können dabei Plasmodium, den Erreger der Malaria, übertragen. Die weiblichen Mücken saugen nämlich nicht nur Blut, sie injizieren auch die Sporozoit genannte Lebensform des einzelligen Parasiten.
Ein Parasit, mehrere Lebensformen
Plasmodium unterläuft im Menschen und in der Anophelesmücke unterschiedliche Entwicklungsstadien. Durch den Mückenstich gelangen die Sporozoiten in die Blutbahn des Menschen. Dort entwickelt und vermehrt sich der Parasit zunächst in Leberzellen und dann in den roten Blutkörperchen, den Erythrozyten, die für unsere Sauerstoffversorgung verantwortlich sind. In ihnen reift Plasmodium zu einem Stadium heran, das der sexuellen Vermehrung dient, den sogenannten Gametozyten. Wird ein infizierter Mensch erneut Opfer einer Blutmahlzeit der Anophelesmücke, gelangen die Gametozyten mit den roten Blutkörperchen in den Darm der Mücke. Hier findet die sexuelle Vermehrung statt. Am Ende schließt sich der Kreis, indem der Erreger in die Speicheldrüse der Mücke einwandert; bereit, den nächsten Menschen zu infizieren. Die Mücke überträgt so die Krankheit von einem Menschen auf den anderen und wird deshalb auch als Vektor bezeichnet.
Besondere klimatische Bedingungen müssen zusammenkommen, damit Anophelesmücken sich vermehren und Plasmodien ihren Lebenszyklus durchmachen. Diese Bedingungen findet man vor allem in tropischen und subtropischen Gegenden. Mehr als 40 % aller Menschen weltweit leben in Regionen, in denen die Malaria endemisch auftritt.
Während des Lebenszyklus des Parasiten brechen die infizierten Erythrozyten regelmäßig und oft gleichzeitig auf. Freigesetzte Parasiten infizieren dann weitere Blutkörperchen. Zusammen mit den Parasiten werden auch giftige Stoffwechselprodukte ins Blut geschwemmt. Die Folge sind meist periodisch auftretendes Fieber, Übelkeit und Kopfschmerzen — typische Symptome der Malaria, die auf die Reaktion des Immunsystems zurückzuführen sind. Diese entzündliche Reaktion fällt übrigens schwächer aus, wenn Patienten gleichzeitig auf einem ihrer Chromosomensätze das Gen für eine bestimmte Erbkrankheit, die sogenannte Sichelzellenanämie, tragen. Dann ist ein Teil ihrer Sauerstofftransport-Proteine defekt und einige der Erythrozyten nehmen eine sichelförmige Form an, worauf der Name der Krankheit zurückgeht. Da die zugrundeliegende Mutation ihre Träger vor Malaria schützt, konnte sie sich in Malariagebieten stark ausbreiten.
Verschiedene Plasmodien verursachen Malaria beim Menschen
Es gibt vier Plasmodium-Arten, die beim Menschen Malaria hervorrufen können: Plasmodium falciparum, Plasmodium vivax, Plasmodium malariae und Plasmodium ovale. Eine weitere Art, Plasmodium knowlesi, infiziert in erster Linie Affen, kann aber auch Menschen betreffen. Als besonders gefährlich gilt die durch Plasmodium falciparum hervorgerufene Malaria tropica, bei der es zu verschiedenen Komplikationen kommen kann. Unbehandelt verläuft diese Form in bis zu 20 % der Fälle tödlich. Sie kann jedoch gut mit einer Kombinationstherapie verschiedener Artemisinin-haltiger Wirkstoffe behandelt werden. Da aber mittlerweile zunehmend Resistenzen gegen diese gängigen Therapeutika beobachtet werden, besteht dringender Forschungsbedarf an neuen Wirkstoffen. Am Helmholtz-Institut für Pharmazeutische Forschung Saarland (HIPS) haben Forscher:innen entdeckt, dass Substanzen aus der Naturstoffklasse der Chlorotonile nicht nur gegen verschiedene Krankenhauskeime wirksam sind, sondern auch gegen Plasmodium falciparum. Sie arbeiten nun mit Partnern des Universitätsklinikums Tübingen daran, die Wirkstoffe für die Behandlung der Malaria zu optimieren.
Endlich eine zugelassene Impfung ...
Die beste Vorbeugung ist der Schutz vor dem Mückenstich, beispielsweise durch Moskitonetze und den Einsatz von Insektizid-Sprays. Seit einigen Jahren gibt es jedoch endlich eine weitere Alternative, um Kinder zu schützen: Im Oktober 2021 hat die WHO den Einsatz des Impfstoffs RTS,S in Malariaendemiegebieten empfohlen. Mit insgesamt vier Impfstoffdosen, davon drei im ersten Lebensjahr und eine Boosterimpfung im Alter von etwa 2 Jahren, können bis zu 75 % der Malariafälle bei Kindern verhindert werden. Seit 2023 steht mit R21 ein weiterer Impfstoff mit vergleichbarer Wirksamkeit zur Verfügung. Weitere Impfstoffkandidaten sind in der Entwicklung und klinischen Prüfung.
Durch den Klimawandel können sich in Zukunft die Malariaendemiegebiete verschieben. Extremwetterereignisse mit Überschwemmungen können neue Brutstätten für die übertragenden Moskitos schaffen. Wenn es jedoch gelingt, neue Wirkstoffe mit einem flächendeckenden Zugang zu den Impfstoffen zu kombinieren, stehen wirksame Werkzeuge zur Verfügung, um die berüchtigte Infektionskrankheit zurückzudrängen und viele Leben zu retten.
Stand: März 2026
(bma, cwe)
Weitere Informationen
FAQ der Weltgesundheitsorganisation zu Malaria-Impfstoffen (auf Englisch)
Beteiligte Forschungsgruppen
-
Mikrobielle Naturstoffe
 Prof. Dr. Rolf Müller
Prof. Dr. Rolf Müller -
Wirkstoffdesign und Optimierung
 Prof. Dr. Anna K. H. Hirsch
Prof. Dr. Anna K. H. Hirsch